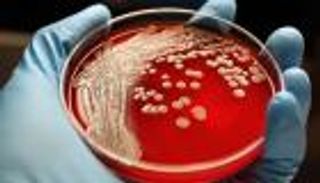

اكتشفه العلماء بالصدفة.. الضوء الأزرق يقضي على "الجراثيم الخارقة"

العلماء ينجحون في إضعاف "البكتيريا الخارقة" عن طريق تسليط "ضوء أزرق" عليها ما يبشر بسهولة القضاء عليها في القريب العاجل
في رحلة البحث المضنية عن طرق مبتكرة لمحاربة "الجراثيم الخارقة"، كشفت دراسة حديثة عن أن الضوء الأزرق يمكنه أن يضعف مسببات الأمراض، ما يجعلها أكثر عرضة للتدمير بواسطة العلاجات المطهرة المتوفرة.
ونقلت مجلة "ميديكال نيوز توداي" العلمية الأمريكية عن جامعة بوردو في ويست لافاييت وجامعة بوسطن في ماساتشوستس أن مقاومة المضادات الحيوية آخذة في الارتفاع على الصعيد العالمي، وهذا يعني أن المضادات الحيوية التي عالجت بعض الإصابات مرة لم يعد لها أي تأثير.

ويتطلع العلماء إلى تنفيذ تقنيات مبتكرة ويسعون جاهدين لإيجاد طرق بديلة لتدمير مسببات الأمراض الفتاكة.
وركز العلماء أبحاثهم على السلالة المعروفة أكثر من البكتيريا المقاومة للمضادات الحيوية، أو المكورات العنقودية الذهبية المقاومة للميثيسيلين.
ويمكن للأطباء علاج معظم هذه الإصابات بنجاح، ولكن يمكن أن تؤدي التهابات المكورات العنقودية الحادة إلى بتر الأعضاء أو حتى الوفاة.

واكتشف العلماء عن طريق الصدفة أنه في الإمكان إضعاف البكتيريا بتسليط "ضوء أزرق" عليها، ليصبح الغشاء الخاص بها نفاذاً، ما يجعل البكتيريا غير معزولة.
وبعد هذا التسليط الضوئي، عرضوا البكتيريا لمطهرات خفيفة نسبيا، مثل بيروكسيد الهيدروجين. وقاموا كذلك باختبار الضوء الأزرق في مجموعة من الحالات الأخرى، بما في ذلك البكتيريا المستزرعة، والخلايا المناعية المصابة بالبكتيريا العنقودية ونموذجين للعدوى بالجروح في الفئران.
ولعل الجزء الأكثر إثارة للاهتمام من هذا الاكتشاف هو بساطة التكنولوجيا المستخدمة في القضاء عليها، وأوضح العلماء أن الجهاز نفسه صغير جدا وسهل الاستخدام ويمكن تطويره حتى يحمله أي شخص في السنوات القليلة المقبلة.